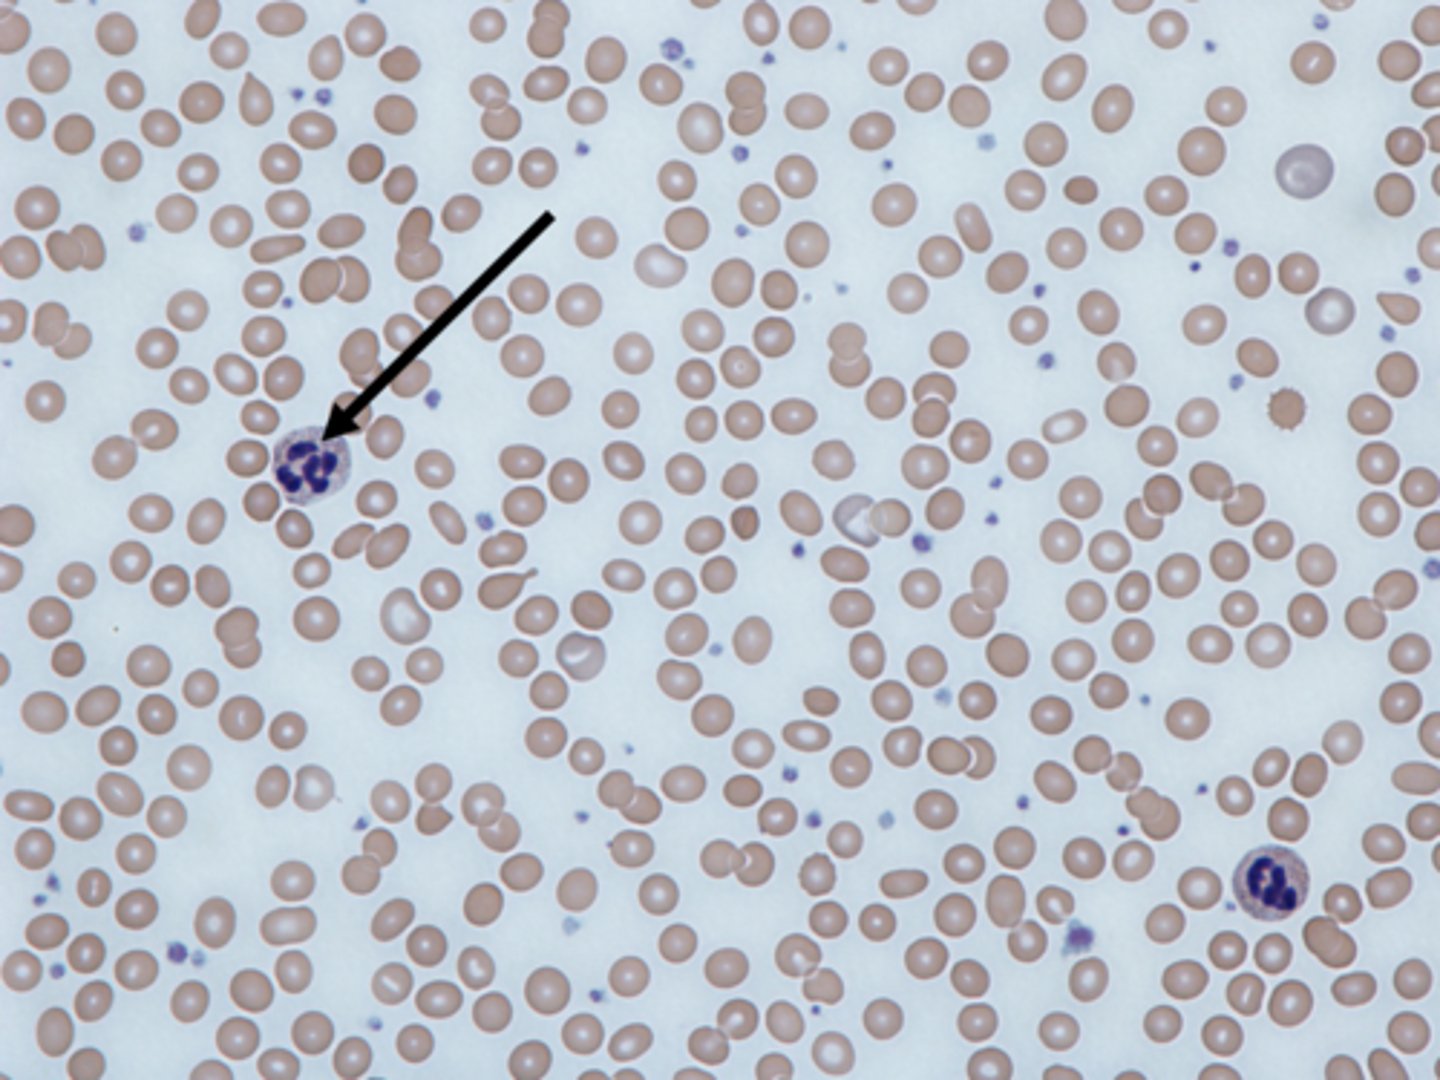
<p>White blood cells</p>
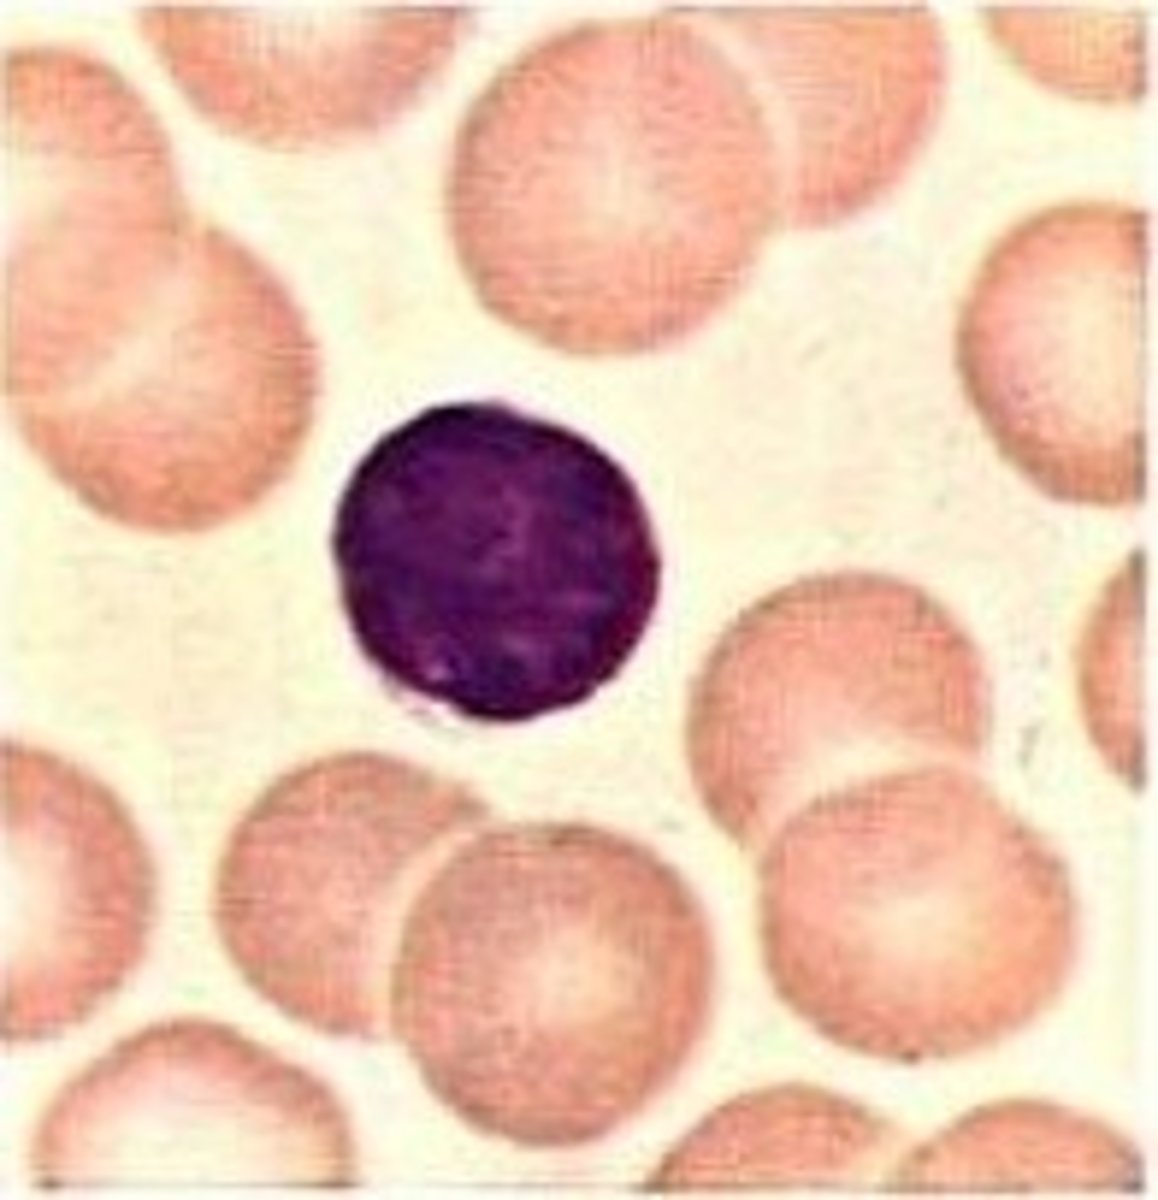
<p>Leukocytes without cytoplasmic granules</p>
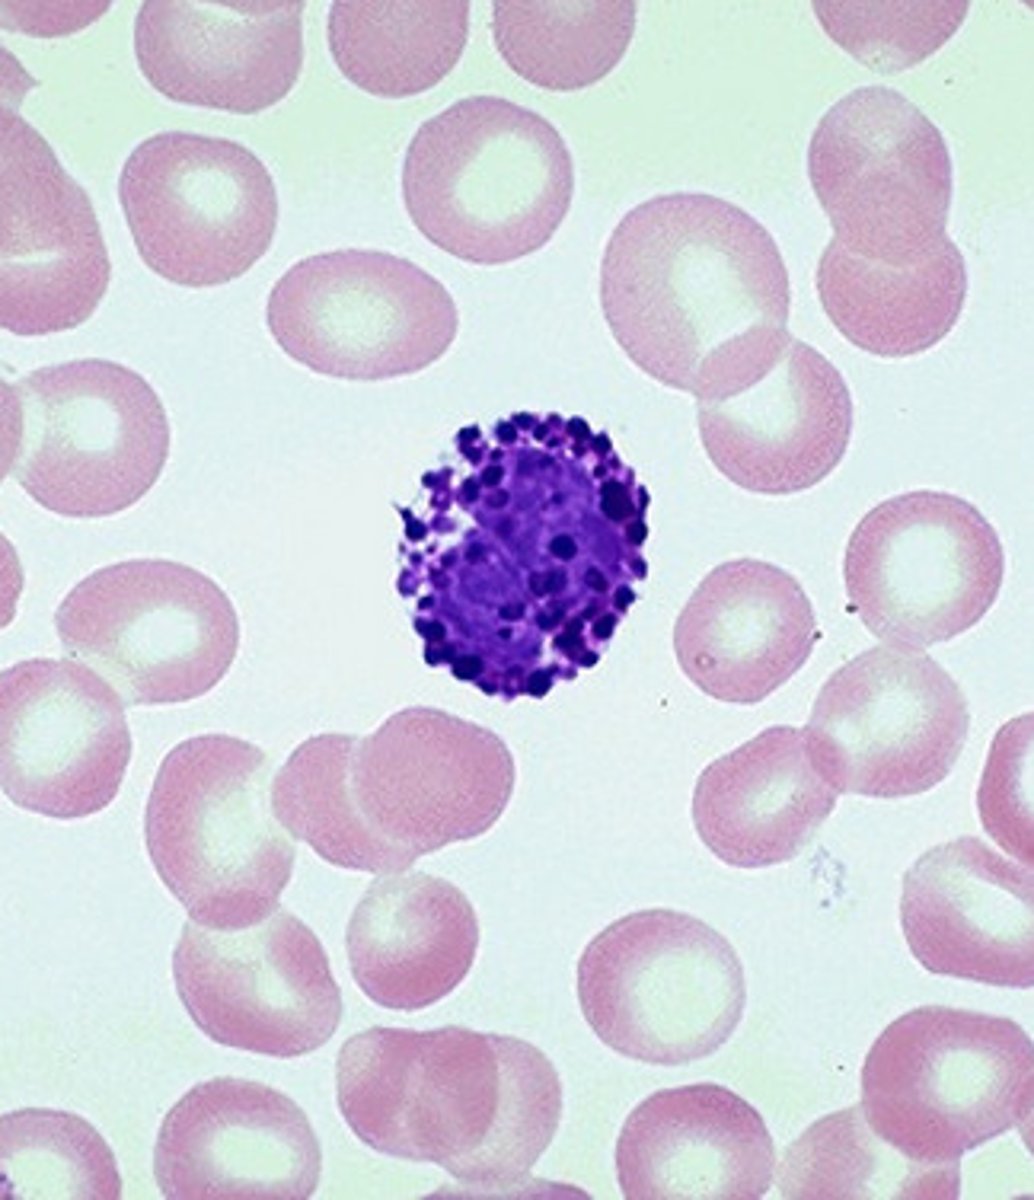
<p>A granulocyte similar to eosinophils in size and in the shape of their nuclei, but they have fewer, more irregularly shaped cytoplasmic granules that stain deep blue in basic stain.</p>

Abrielle's Human Blood Cells and Components Flashcards
1/14
There's no tags or description
Looks like no tags are added yet.
Name | Mastery | Learn | Test | Matching | Spaced | Call with Kai |
|---|
No analytics yet
Send a link to your students to track their progress
15 Terms
Erythrocyte
A red blood cell

Leukocyte
White blood cells
Granulocyte
Leukocytes with granular cytoplasm

Agranulocyte
Leukocytes without cytoplasmic granules
Neutrophil
A granulocyte with fine cytoplasmic granules that stain light purple in neutral stain.

Eosinophil
A granulocyte that contains coarse, uniformly sized cytoplasmic granules that stain deep red in acid stain.

Basophil
A granulocyte similar to eosinophils in size and in the shape of their nuclei, but they have fewer, more irregularly shaped cytoplasmic granules that stain deep blue in basic stain.
Lymphocyte
An agranulocyte that is slightly larger than a red blood cell. They contain a large, round nucleus surrounded by a thin rim of cytoplasm.

Monocyte
An agranulocyte that is two to three times larger than a red blood cell. Their nuclei vary in shape and are round, kidney-shaped, oval, or lobed.

Platelets
Cytoplasmic fragment formed in bone marrow that helps blood clot.

Plasma
Fluid portion of circulating blood.

Formed Elements
Red blood cells, platelets, and white blood cells together

Blood Types
Blood types (A+, A-, B+, B-, AB+, AB-, O+, O-) are determined by inherited antigens and Rh factors

Granules
Small, enzyme-filled particles found within granulocytes

Nucleus
A cellular organelle enclosed by a double-layered, porous membrane and containing DNA. Used to identify the type of white blood cell.
